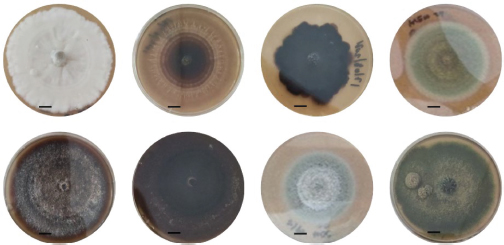

Ciencia, Ambiente y Clima, Vol. 7, No. 2, julio-diciembre, 2024 ISSN (impreso): 2636-2317 • ISSN (en línea): 2636-2333 • Sitio web: https://revistas.intec.edu.do/
ESCLAUDYS PÉREZ GONZÁLEZ1 Y ELÍ MISAEL BOBADILLA-PEÑALÓ2
Recibido: 14 de octubre 2024 • Aceptado: 29 de enero 2025
Cómo citar: Pérez González, E. y Bobadilla-Peñaló, E. M. (2024). Primer reporte de hongos ophiostomatoides asociados con Ips calligraphus (Germar, 1823) (Coleoptera: Curculionidae) infestando Pinus occidentalis Sw. en la vertiente noroeste de la Cordillera Central, República Dominicana. Ciencia, Ambiente y Clima, 7(2), 31-48. https://doi.org/10.22206/cac.2024.v7i2.3336
Resumen
Ips calligraphus es la plaga principal de los bosques de Pinus occidentalis Sw. en República Dominicana y actúa como vector potencial de hongos ophiostomatoides. La asociación simbiótica de Ips con hongos ophiostomatoides puede alterar la defensa del árbol huésped al superar la toxicidad de los metabolitos secundarios, contribuyendo al éxito de colonización y reproducción del escarabajo y constituyéndose en un dúo letal para las coníferas y de grandes pérdidas económicas para la industria forestal. Por tanto, resulta crítico identificar las especies de hongos involucradas y comprender sus implicaciones para el manejo de los focos de infestación por I. caligraphus. En esta investigación, se aislaron hongos en medio de cultivo agar extracto de malta, a partir del cuerpo de insectos recolectados en árboles atacados. Los hongos fueron identificados con base en los atributos morfológicos del micelio y secuenciación de ADN usando cebadores ITS1-ITS4. Se identificaron seis morfotipos de hongos ophiostomatoides: cuatro Ophiostoma ips, un Leptographium manifestum y un Ophiostoma spp. Este es el primer reporte de hongos ophiostomatoides asociados a I. calligraphus en el país.
Palabras claves: Ophiostoma ips, ITS-1, ITS-4, Leptographium, Extracto de Malta Agar (MEA).
Abstract
Ips calligraphus is the primary pest of Pinus occidentalis Sw. forests in the Dominican Republic and acts as a potential vector for ophiostomatoid fungi. The symbiotic association between Ips and these fungi compromises the host tree’s defense mechanisms by overcoming the toxicity of secondary metabolites, facilitating the beetle’s colonization and reproduction. This lethal combination poses a significant threat to conifers and results in substantial economic losses for the forestry industry. To address this issue, fungi were isolated on malt extract agar from insect bodies collected from infested trees. Identification was based on the morphological characteristics of the mycelium and DNA sequencing using ITS1-ITS4 primers. Six morphotypes of ophiostomatoid fungi were identified: four Ophiostoma ips, one Leptographium manifestum, and one Ophiostoma spp. This study provides the first report of ophiostomatoid fungi associated with I. calligraphus in the country.
Keywords: Ophiostoma ips, ITS-1, ITS-4, Leptographium, Malt Extract Agar (MEA).
Ips calligraphus (Germar, 1823) es un coleóptero de la familia Curculionidae, nativo de América del Norte (EE. UU. y Canadá), distribuido por México, China, Guatemala, Honduras y La Española (Lanier et al., 1991, Wood y Stark, 1968, Billings, 1997; Cervantes-Martínez et al., 2019). Este escarabajo de la corteza puede atacar la mayoría de las especies de Pinus (Wood y Stark, 1968; Haack et al., 1984), y se ha convertido en el principal problema fitosanitario de los bosques de Pinus occidentalis Sw.de República Dominicana (Jiménez et al., 2022). En el 2018-2019, los ataques de I. calligraphus fueron considerados como epidémicos por la destrucción de más de 500 hectáreas de bosques naturales y plantaciones de Pinus (P. occidentalis y P. caribaea Morelet), dejando a su paso importantes pérdidas económicas y daños al ecosistema (Jiménez et al., 2022).
El coleóptero I. calligraphus, denominado también escarabajo de la corteza de seis espinas (CABI, 2023), coloniza los árboles de Pinus spp. perforando la corteza y excavando galerías que interfieren con la circulación de nutrientes, mientras se alimenta y se reproduce (Krokene et al., 1996; Khadempour et al., 2012; Hammerbacher et al., 2013; Moreno-Rico et al., 2015). La madera colonizada por el escarabajo presenta comúnmente el manchado azul, que se vincula a la presencia de hongos (Kirisits y Offenthaler, 2002). Particularmente, Ips spp. viven en asociación con comunidades de hongos que pueden estar directamente relacionados con la muerte del árbol (Kirisits, 2007; Hammerbacher et al., 2013; Moreno-Rico et al., 2015).
En I. acuminatus se han detectado 60 especies de estos hongos con distintos niveles de patogenicidad (Davydenko et al., 2017), 16 morfotipos de hongos en I. Ips sexdentatus (Levieux et al., 1989); 13 especies en I. perturbatus (Massoumi et al., 2007); y siete tipos de esporas de hongos diferentes en I. typographus japonicus (Moser et al., 1997), por citar algunos registros. Uno de los sistemas del complejo Ips-hongo mejor estudiado es el que involucra la asociación de I. typographus de Picea abies con hongos ophiotomatoides de los géneros Endoconidiophora, Ophiostoma y Grosmannia (Kirisits, 2004; Franceschi et al., 2005; Six y Wingfield, 2011; Krokene, 2015), algunos de estos hongos son capaces de degradar compuestos fenólicos del floema en detrimento de los mecanismos de defensa de la planta (Krokene, 2015; Zhao et al., 2018).
En ese sentido, se ha visto que mientras el adulto y larvas del Ips se alimentan del flujo floemático, los hongos asociados pueden secar el tejido vegetal induciendo el taponamiento de los haces vasculares de la planta (Pashenova et al., 2018). Varios autores han demostrado el sinergismo entre complejo Ips-hongo para romper las barreras defensivas físicas y bioquímicas de los árboles (Christiansen y Bakke, 1988; Wermelinger, 2004; Hammerbacher et al., 2013), destacando que los hongos ophiostomatoides desempeñan un importante papel en la biología y comportamiento de los escarabajos, al alterar las defensas químicas del árbol huésped, promoviendo el éxito de colonización y reproducción del escarabajo (Jirošová et al., 2022; Zheng et al., 2020). Estudiar las dinámicas evolutivas y ecofisiológicas de estas relaciones simbióticas es indispensable para trazar estrategias de manejo fitosanitario efectivas. No obstante, la sistemática de los hongos del orden Ophiostomatales es compleja, debido a que los hongos exhiben una morfología homogénea, lo que dificulta su identificación con caracteres fenotípicos tradicionales, requiriendo de técnicas moleculares por comparación de secuencias de ADN (Massoumi et al., 2007). La caracterización de las poblaciones de estos hongos mediante la secuenciación de las regiones del espaciador transcrito interno (ITS, por sus siglas en inglés) es una alternativa confiable y exitosa (Hausner et al., 1993; Zheng et al., 2020; Runlei et al., 2018).
Considerando la importancia ecológica, social y económica de P. occidentalis, así como el creciente impacto de I. calligraphus en los bosques nativos y plantaciones, resulta imperativo evaluar la riqueza de micobiontes patógenos, dada su influencia en la dinámica de colonización y ciclo de vida de I. calligraphus. El conocimiento que se tiene en el país sobre las interacciones ecofisiológicas entre I. calligraphus con hongos fitopatógenos es limitado, por lo que con este estudio se pretende proporcionar un diagnóstico preliminar de los hongos ophiotomatoides asociados con ejemplares de I. calligraphus recolectados in situ.
Durante el año 2022, se realizaron visitas de reconocimiento para identificar focos de ataques de I. calligraphus, tanto en bosques naturales como en plantaciones de P. occidentalis. En total, se seleccionaron nueve puntos distribuidos en seis lugares (Figura 1): Yerba Buena (1 punto), Clavijo (3 puntos), Los Corrales (1 punto), Gurabo (1 punto), La Estaca de Vallecito (1 punto) y La Celestina (2 puntos). En cada uno de estos puntos, se seleccionaron aleatoriamente individuos afectados en fase II (fase de colonización masiva) por I. calligraphus con un diámetro a la altura del pecho (DAP 1.3 m) igual o superior a 25 cm. A la altura del DAP del árbol se removió la corteza y con una pinza estéril se extrajeron los individuos adultos del escarabajo, que posteriormente fueron colocados en una placa Petri estéril.
Figura 1
Área de estudio: bosques naturales y plantados de P. occidentalis

Se recolectaron entre 5-10 escarabajos por localidad. Posteriormente, fueron lavados con agua destilada estéril y luego tratados con una solución de hipoclorito de sodio comercial al 1.5 % durante dos minutos. Posteriormente, fueron enjuagados tres veces con agua destilada estéril y secados en una cabina de flujo laminar. Los escarabajos fueron colocados individualmente en placas Petri con medio de cultivo a base de Extracto de Malta Agar (MEA) suplementado con 0.5 g/L cicloheximida y 0.4 g/ L cloranfenicol. Finalmente, fueron incubados en oscuridad a 25 ± 2 °C durante 30 días. Las estructuras crecidas fueron subcultivadas hasta obtener colonias puras.
Los morfotipos puros obtenidos se cultivaron en un medio de cultivo de agar con extracto de malta (MEA) libre de antibiótico y se colocaron en la oscuridad a 25 ± 2 °C. Se evaluaron características como el diámetro y color de las colonias, el tipo de micelio, la arquitectura de las estructuras reproductivas, así como la forma de los conidios y ascosporas. Se recolectaron muestras de los cultivos a los ocho días, se montaron en portaobjetos con lactofenol y se observaron en un microscopio Motic Phantera C2. Para la identificación, se consultaron las claves taxonómicas de Barnett y Hunter (1998)) a nivel de género, y para especie, las de Upadhyay (1981)) y Jacobs y Wingfield (2001)).
Las muestras de micelios fueron colectadas y depositadas en tubos de microcentrífuga de 2 mL, a los que se le agregaron 500 µL de buffer fosfatado salino (PBS) para eliminar los residuos del medio de cultivo. Se centrifugó a 5000 rpm y se conservaron las estructuras de los aislados y se descartó el sobrenadante. Una vez se completó el centrifugado, se siguió el protocolo de extracción de ADN “PureLink® Genomic DNA mini Kit,Invitrogen, Thermo Fisher Scientific”, Carlsbad, California, Estados Unidos. El ADN extraído fue empleado como molde para hacer la reacción en cadena de la polimerasa (PCR, por sus siglas en inglés) usando los cebadores ITS1 e ITS4. Se siguió el programa de PCR de tres minutos a 94 °C, luego 30 ciclos de 30 segundos (s) a 94 °C, 30 s a 55 °C y 45 s a 72 °C, y finalmente cinco minutos a 72 °C en un volumen total en de 25 µl de reacción; compuestos de una 12.5 µl máster mix polimerasa, DNTPS, 1.5 µl de cada iniciador y 7.5 µl de agua. En los casos positivos, los cebadores ITS-1/ITS-4 (ITS1: CCGTAGGTGAACCTGCGG e ITS4: TCCTCCGCTTATTGATATGC) amplifican un fragmento de ADN de aproximadamente 450 pares de bases (pb). Los productos de la PCR fueron visualizados luego de realizar una electroforesis en un gel de agarosa al 1 % usando TAE (Tris-Ácido acético-EDTA) teñido Midori Green Direct Midori Green Direct. Una vez confirmada la amplificación de los fragmentos de cada aislado, se repitió la PCR en un volumen de 50 µl para ser limpiados empleando el kit de limpieza Gene clean (Biomedical-Solon-Ohio) y enviados para su secuenciación (Macrogen Inc. USA, Maryland, USA). Obtenidos los resultados de la secuencia, se procedió a buscar similitudes entre las secuencias y los registros existentes en la base de datos del Centro Nacional de Información en Biotecnología (NCBI, por sus siglas en inglés), usando un Sistema de Herramientas Básicas de Alineamientos (BLAST, por sus siglas en inglés).
Después de la caracterización morfológica, se seleccionaron seis muestras de hongos con mayores diferencias entre ellas para realizar la caracterización molecular. La PCR se realizó utilizando los cebadores ITS1 e ITS4, los cuales amplificaron fragmentos de aproximadamente 450 pb. Estos fragmentos se visualizaron mediante electroforesis en gel de agarosa al 1 % (Figura 4). Posteriormente, se purificaron 20 µL de cada producto de amplificación y se enviaron a Macrogen Inc. (Maryland, USA) para su secuenciación en ambas direcciones, utilizando los mismos cebadores. Las secuencias obtenidas fueron comparadas con registros existentes en la base de datos del Centro Nacional de Información en Biotecnología (NCBI) mediante el uso de la herramienta BLAST.
Se obtuvieron de manera preliminar 91 colonias puras que, debido a su similitud morfológica, fueron reagrupadas en 29 muestras representativas de los seis lugares muestreados. Posteriormente, se llevó a cabo una reagrupación más exhaustiva de estas 29 muestras, resultando en nueve muestras que presentaban al menos una característica diferencial entre ellas (Tabla 1 y Figuras 2 y 3). Durante el proceso de aislamiento, se descartaron colonias de Penicillium y Aspergillus debido a su escasa relación con el escarabajo Ips. Se identificaron hongos ophiostomatoides que incluyeron siete morfotipos del género Ophiostoma spp. (uno por cada localidad, a excepción de La Celestina que se identificaron dos) y dos morfotipos de Leptographium spp. ambos encontrados en Los Corrales.
Tabla 1
Aislamiento de hongos asociados a I. calligraphus en P. occidentalis, en diferentes localidades de la vertiente Note de la Cordillera Central
Localidad |
Número Aislados |
Descartados |
Colonias puras |
Agrupada por similitud |
Código de identificación |
Yerba Buena |
5 |
3 |
12 |
4 |
HIYB |
Clavijo |
10 |
4 |
17 |
6 |
HICla |
Los Corrales |
5 |
1 |
13 |
3 |
HICor |
Gurabo |
7 |
3 |
18 |
5 |
HIGur |
La Estaca de Vallecito |
7 |
4 |
12 |
4 |
HIEVa |
La Celestina/El Pinar |
8 |
3 |
19 |
7 |
HICel |
Total |
42 |
18 |
91 |
29 |
Las dos primeras letras del código corresponden a hongos asociados a Ips (HI) y las letras siguientes en referencia a la localidad. YB (Yerba Buena), Cla (Clavijo); Cor (Los Corrales); Gur (Gurabo); Eva (Estancia de Vallecito) y Cel (La Celestina). A cada código se le asigna un número del aislado p.e. HIYB1, corresponde al aislado 1 de Yerba Buena.
Figura 2
Morfotipos de hongos del orden Ophiostomales aislados de I. calligraphus en medio de cultivo MEA. La raya negra sobre cada placa petri indica 1 cm
Figura 3
Estructuras morfológicas características de los hongos ophiostomatoides aislados de Ips calligraphus. A- Hyalorhinocladiella-con morfo asexual y conidios. B.- Ápice del cuello con hifas ostiolares ramificadas y ascosporas. C.- Clamidosporas. D.- Conidióforos sinematodos. E, F y G.- Peritecios de cuello largo en los ascocarpos con hifas. H.- Ascosporas alantoides

Según la base de datos GenBank del Centro Nacional de Información en Biotecnología (NCBI), las secuencias analizadas mostraron un alto grado de similitud (99.12 % a 100 %) con hongos de los géneros Ophiostoma y Leptographium, identificándose específicamente como Ophiostoma ips, Ophiostoma spp. y Leptographium manifestum. Este nivel de coincidencia confirma la identidad de los organismos secuenciados como hongos ophiostomatoides, conocidos por su estrecha relación simbiótica o patógena con escarabajos del género Ips. Como se detalla en la Tabla 2, cuatro de las secuencias obtenidas (HIYB3, HIGur1, HIEVa1 y HICel5) corresponden a Ophiostoma ips, con similitudes que oscilan entre el 98.4 % y el 99.39 %. Una secuencia adicional (HICla5) mostró una coincidencia del 100 % con Ophiostoma spp., lo que sugiere que pertenece al mismo género, aunque no fue posible determinar su identidad a nivel de especie. Finalmente, una secuencia (HICor3) presentó una similitud del 99.39 % con Leptographium manifestum, un hongo también asociado a interacciones ecológicas complejas en sistemas forestales, particularmente con especies de Ips.
Figura 4
Gel de agarosa que muestra la amplificación de ADN de hongos con los cebadores ITS e I. M.-Representa el marcador molecular de 800 pb. CN.- Representa el Control Negativo. HIYB3.- Amplificación para ADN del morfotipo 3 proveniente de Yerba Buena. HICla5.- Amplificación para ADN del morfotipo 5 proveniente de Clavijo. HICor3.-Amplificación para ADN del morfotipo 3 proveniente de Los Corrales. HIGur1.- Amplificación para ADN del morfotipo 1 proveniente Gurabo. HIEVa1.- Amplificación para ADN del morfotipo 1 proveniente Estancia de Vallecito y HICel5.- Amplificación para ADN del morfotipo 5 proveniente de La Celestina

Tabla 2
Comparación de las secuencias de hongos ophiostomatoides con la base de datos NCBI
Localidad |
Código de identificación |
Número de acceso |
% de similitud |
Secuencias alineadas en BLAST |
Yerba Buena |
HIYB3 |
JQ289015.1 |
99.12 % |
Ophiostoma ips |
Clavijo |
HICla5 |
MK371509.1 |
100 % |
Ophiostoma spp. |
Los Corrales |
HICor3 |
MN907679.1 |
99.39 % |
Leptographium manifestum |
Gurabo |
HIGur1 |
KC768089.1 |
99.39 % |
Ophiostoma ips |
La Estaca de Vallecito |
HIEVa1 |
MK324813.1 |
98.4 % |
Ophiostoma ips |
La Celestina/El Pinar |
HICel5 |
AY546698.1 |
99 % |
Ophiostoma ips |
En este estudio, se documenta por primera vez la presencia de hongos ophiostomatoides (Ophiostoma ips, Ophiostoma spp. y Leptographium manifestum) asociados con Ips calligraphus en Pinus occidentalis en la vertiente noroeste de la Cordillera Central, República Dominicana. Estas asociaciones representan un aporte significativo al establecer la relación simbiótica entre los hongos ophiostomatoides y Ips calligraphus, destacando su posible implicación en el deterioro de Pinus occidentalis. Este reporte amplía el conocimiento sobre las comunidades fúngicas vinculadas a este escarabajo en el Caribe y subraya la importancia de investigar estas interacciones para promover el manejo sostenible de los ecosistemas forestales locales.
La identificación de estos hongos se basó en un análisis de características morfológicas y moleculares, en línea con estudios previos que resaltan la relevancia de estos métodos para comprender la diversidad y el papel ecológico de los hongos asociados con Ips. Estas herramientas son fundamentales no solo para la clasificación y manejo de patógenos en ecosistemas forestales, sino también para el diseño de estrategias efectivas de biocontrol y gestión fitosanitaria (De Beer et al., 2014; Romón et al., 2007; Runlei et al., 2018). Los hallazgos obtenidos refuerzan la importancia de continuar explorando las interacciones simbióticas entre Ips y hongos ophiostomatoides en diferentes contextos ecológicos y geográficos, dada su relevancia para la sanidad y sostenibilidad de los ecosistemas forestales a nivel global.
La identificación de estos hongos ophiostomatoides en las distintas localidades estudiadas subraya su estrecha relación con Ips y destaca su importancia en el contexto del manejo y control fitosanitario de los ecosistemas forestales afectados. A pesar de la relevancia de este primer reporte sobre Ophiostoma ips, Ophiostoma spp. y Leptographium manifestum, se deben considerar algunas limitaciones en la identificación de los hongos basada en características morfológicas y en las secuencias ITS. Estas herramientas, aunque útiles, pueden no ser suficientes para diferenciar especies crípticas o recientemente descritas, lo que podría llevar a una subestimación de la diversidad real de estos organismos. Esto es especialmente importante en el caso de Ophiostoma spp., donde la falta de datos moleculares adicionales, como genes de loci secundarios, dificulta una identificación más precisa. Otro aspecto a destacar es la exclusión de colonias identificadas como Penicillium y Aspergillus debido a su limitada asociación conocida con Ips. Si bien esta decisión está alineada con el objetivo principal del estudio, podría restringir la comprensión de las interacciones ecológicas más amplias dentro de los microhábitats de estos escarabajos. En términos prácticos, los resultados resaltan la necesidad de desarrollar estrategias de manejo fitosanitario más integrales a nivel local. Estos datos pueden servir como base para diseñar programas específicos que interrumpan el ciclo simbiótico entre los hongos ophiostomatoides y los escarabajos hospedadores. Sin embargo, implementar estas estrategias requiere una mejor comprensión de la biología y ecología de estas especies en el contexto regional, teniendo en cuenta además los posibles efectos del cambio climático en su distribución y propagación
Este estudio constituye el primer reporte de hongos ophiostomatoides asociados con I. calligraphus en P. occidentalis en la vertiente norte de la Cordillera Central, República Dominicana. Los hallazgos destacan la diversidad de estos hongos relacionados con el escarabajo y sugieren una posible influencia en la salud y mortalidad de los pinos. Es necesario realizar más estudios para identificar completamente la especie no determinada y comprender mejor el rol de estos hongos en la dinámica de infestación del escarabajo y su efecto en los ecosistemas locales de pinos.
Deseamos expresar nuestro más sincero agradecimiento al Ministerio de Educación Superior, Ciencia y Tecnología (MESCyT) de República Dominicana por su apoyo incondicional a través del Fondo Nacional de Desarrollo Científico y Tecnológico (FONDOCyT). Su compromiso con la promoción de la investigación científica ha sido fundamental para el desarrollo de este proyecto titulado “Caracterización Molecular de Comunidades de Hongos Fitopatógenos Asociados al Descortezador de Pinus Ips calligraphus, su Interrelación en la Muerte del Pinus (occidentalis, caribaea y caribaea var. hondurensis) y Evaluación de Medidas de Biocontrol del complejo Ips calligraphus–Hongo”, en la convocatoria del 2022 con el código VCT-FONDOCYT-001. Gracias a su financiamiento y respaldo, hemos podido llevar a cabo esta investigación, que contribuirá al avance del conocimiento en nuestra área de estudio. Agradecemos al Plan Sierras y la colaboración de sus técnicos en este esfuerzo. Corresponder igualmente al Dr. Luis Matos por su invaluable aporte a esta investigación.
Barnett, H. L., & Hunter, B. (1998). Illustrated genera of imperfect fungi (4th ed.). Minnesota, US: Burgess Publishing Company, APS Press.
Billings, R.F. 1997 Ataque de gorgojo de la corteza de pino (IPS) en la República Dominicana Pp 131- 144 Seminario Nacional sobre Reforestación y Manejo de Bosques. Plan Sierra, 29 septiembre de 1997, San José de Las Mata, República Dominicana.
CABI. (2023). Ips calligraphus (six-spined engraver). Invasive Species Compendium. Retrieved from https://www.cabi.org/isc
Cervantes-Martínez, R., Cerano-Paredes, J., Sánchez-Martínez, G., Villanueva-Díaz, J., Esquivel-Arriaga, G., Cambrón-Sandoval, V. H., ... & Castruita-Esparza, L. U. (2019). Historical bark beetle outbreaks in Mexico, Guatemala and Honduras (1985–2015) and their relationship with droughts. Revista Chapingo Serie Ciencias Forestales y del Ambiente, 25(2), 269–290. https://doi.org/10.5154/r.rchscfa.2019.01.006
Christiansen, E., & Bakke, A. (1988). The spruce bark beetle of Eurasia. In A. A. Berryman (Ed.), Dynamics of forest insect populations: Patterns, causes, implications (pp. 479–503). Springer. https://doi.org/10.1007/978-1-4899-0789-9
Davydenko, K., Vasaitis, R., & Menkis, A. (2017). Fungi associated with Ips acuminatus (Coleoptera: Curculionidae) in Ukraine with a special emphasis on pathogenicity of ophiostomatoid species. European Journal of Entomology, 114, 77–88. https://doi.org/10.14411/eje.2017.011
De Beer, Z. W., Wingfield, M. J., & Roux, J. (2014). Taxonomy and pathology of Ophiostoma and related fungi. Fungal Diversity, 70(1), 15–36. https://doi.org/10.1007/s13225-014-0294-y
Franceschi, V. R., Krokene, P., Christiansen, E., & Krekling, T. (2005). Anatomical and chemical defenses of conifer bark against bark beetles and other pests. New Phytologist, 167(2), 353–376. https://doi.org/10.1111/j.1469-8137.2005.01436.x
Haack, R. A., Wilkinson, R. C., Foltz, J. L., & Corneil, J. A. (1984). Gallery construction and oviposition by Ips calligraphus (Coleoptera: Scolytidae) in relation to slash pine phloem thickness and temperature. The Canadian Entomologist, 116(4), 625–632. https://doi.org/10.4039/Ent116625-4
Hammerbacher, A., Ralph, S. G., Bohlmann, J., Fenning, T. M., Gershenzon, J., & Schmidt, A. (2011). Biosynthesis of the major tetrahydroxystilbenes in spruce, astringin and isorhapontin, proceeds via resveratrol and is enhanced by fungal infection. Plant Physiology, 157(2), 876–890. https://doi.org/10.1104/pp.111.181420
Hammerbacher, A., Schmidt, A., Wadke, N., Wright, L. P., Schneider, B., Bohlmann, J., ... & Paetz, C. (2013). A common fungal associate of the spruce bark beetle metabolizes the stilbene defenses of Norway spruce. Plant Physiology, 162(3), 1324–1336. https://doi.org/10.1104/pp.113.218610
Hausner, G., Reid, J., & Klassen, G. R. (1993). On the phylogeny of Ophiostoma, Ceratocystis s.s., and Microascus, and relationships within Ophiostoma based on partial ribosomal DNA sequences. Canadian Journal of Botany, 71(9), 1249–1265. https://doi.org/10.1139/b93-150
Jacobs, K., & Wingfield, M. J. (2001). Leptographium species: Tree pathogens, insect associates, and agents of blue-stain. American Phytopathological Society (APS Press).
Jiménez, A. A., Cabrera, P. R. C., & Agramonte, J. E. (2022). Fluctuación poblacional de Ips calligraphus en pinares de la vertiente norte de la cordillera Central, República Dominicana. Novitates Caribaea, 20, 137–154. https://doi.org/10.33800/nc.vi20.314
Jirošová, A., Modlinger, R., Hradecký, J., Ramakrishnan, R., Beránková, K., & Kandasamy, D. (2022). Ophiostomatoid fungi synergize attraction of the Eurasian spruce bark beetle, Ips typographus, to its aggregation pheromone in field traps. Frontiers in Microbiology, 13, Article 980251. https://doi.org/10.3389/fmicb.2022.980251
Khadempour, L., LeMay, V., Jack, D., Bohlmann, J., & Breuil, C. (2012). The relative abundance of mountain pine beetle fungal associates through the beetle life cycle in pine trees. Microbial Ecology, 64, 909–917. https://doi.org/10.1007/s00248-012-0077-z
Kirisits, T. (2004). Fungal associates of European bark beetles with special emphasis on the Ophiostomatoid fungi. In Bark and wood boring insects in living trees in Europe: A synthesis (pp. 181–236).
Kirisits, T. (2007). Fungal associates of European bark beetles with special emphasis on the Ophiostomatoid fungi. In Lieutier, F., Day, K. R., Battisti, A., Grégoire, J.-C., & Evans, H. F. (Eds.), Bark and wood boring insects in living trees in Europe: A synthesis (pp. 181–236). Springer. https://doi.org/10.1007/978-1-4020-2241-8_10
Kirisits, T., & Offenthaler, I. (2002). Xylem sap flow of Norway spruce after inoculation with the blue-stain fungus Ceratocystis polonica. Plant Pathology, 51, 359–364. https://doi.org/10.1046/j.1365-3059.2002.00722.x
Krokene, P. (2015). Conifer defense and resistance to bark beetles. In F. E. Vega & R. W. Hofstetter (Eds.), Bark beetles: Biology and ecology of native and invasive species (pp. 177–207). Academic Press.
Krokene, P., & Solheim, H. (1996). Fungal associates of five bark beetle species colonizing Norway spruce. Canadian Journal of Forest Research, 26(12), 2115-2122. https://doi.org/10.1139/x26-240
Lanier, G. N., Teale, S. A., & Pajares, J. A. (1991). Biosystematics of the genus Ips (Coleoptera: Scolytidae) in North America: Review of the Ips calligraphus group. The Canadian Entomologist, 123(5), 1103–1124.
Levieux, J., Lieutier, F., Moser, J. C., & Perry, T. J. (1989). Transportation of phytopathogenic fungi by the bark beetle Ips sexdentatus Boerner and associated mites. Journal of Applied Entomology, 108(1–5), 1–11. https://doi.org/10.1111/j.1439-0418.1989.tb00425.x
Massoumi Alamouti, S., Kim, J. J., Humble, L. M., Uzunovic, A., & Breuil, C. (2007). Ophiostomatoid fungi associated with the northern spruce engraver, Ips perturbatus, in western Canada. Antonie van Leeuwenhoek, 91, 19–34. https://doi.org/10.1007/s10482-006-9092-8
Moreno-Rico, O., Sánchez-Martínez, G., Marmolejo-Monsiváis, J. G., Pérez-Hernández, K., & Moreno-Manzano, C. E. (2015). Diversidad de hongos ophiostomatoides en pinos de la Sierra Fría de Aguascalientes, México, asociados con Dendroctonus mexicanus. Revista Mexicana de Biodiversidad, 86(1), 1–8. https://doi.org/10.7550/rmb.46751
Moser, J. C., Macías-Sámano, J. E., Konrad, H., & Kirisits, T. (1997). Phoretic mites and their hyperphoretic fungi associated with flying Ips typographus japonicus Niijima (Col., Scolytidae) in Japan. Journal of Applied Entomology, 133(9–10), 702–710. https://doi.org/10.1111/j.1439-0418.2009.01406.x
Pashenova, N. V., Seraya, L. G., & Baranchikov, Y. N. (2018). Transmission of the Ophiostoma fungi by Ips typographus in the Moscow region. Fungal Biology.
Romón, P., Zhou, X., Iturrondobeitia, J. C., Wingfield, M. J., & Goldarazena, A. (2007). Ophiostoma species (Ascomycetes: Ophiostomatales) associated with bark beetles (Coleoptera: Scolytinae) colonizing Pinus radiata in northern Spain. Canadian Journal of Microbiology, 53(7), 756–767. https://doi.org/10.1139/W07-001
Runlei, C., Tuan, A. D., Stephen, J. T., Michael, J. W., Xudong, Z., & Mingliang, Y. (2018). Ophiostomatoid fungi associated with the spruce bark beetle Ips typographus, including 11 new species from China. Persoonia. https://doi.org/10.3767/persoonia.2019.42.03
Six, D. L., & Wingfield, M. J. (2011). The role of phytopathogenicity in bark beetle–fungus symbioses: A challenge to the classic paradigm. Annual Review of Entomology, 56(1), 255–272.
Upadhyay, H. P. (1981). A monograph of Ceratocystis and Ceratocystiopsis. University of Georgia Press.
Wermelinger, B. (2004). Ecology and management of the spruce bark beetle Ips typographus—A review of recent research. Forest Ecology and Management, 202(1–3), 67–82.
Wood, S. L., & Stark, R. W. (1968). The life history of Ips calligraphus (Coleoptera: Scolytidae) with notes on its biology in California. The Canadian Entomologist, 100(2), 145–151. https://doi.org/10.4039/Ent100145-2
Zhao, L., Ahmad, F., Lu, M., Zhang, W., Wickham, J. D., & Sun, J. (2018). Ascarosides promote the prevalence of ophiostomatoid fungi and an invasive pathogenic nematode, Bursaphelenchus xylophilus. Journal of Chemical Ecology, 44, 701–710.
Zheng, W., Liu, Y., Wang, H. M., Meng, X., Liu, X. W., Decock, C., Zhang, X., & Lu, Q. (2020). Ophiostomatoid fungi associated with Ips subelongatus, including eight new species from northeastern China. Mycological Progress. https://doi.org/10.1186/s43008-019-0025-3
_______________________________
1 Universidad ISA. Av. Pres. Antonio Guzmán Fernández km 5 ½ La Herradura, Santiago de los Caballeros, República Dominicana. ORCID: 0000-0003-0465-6261. Correo-e: eperez@isa.edu.do
2 Universidad ISA. Av. Pres. Antonio Guzmán Fernández km 5 ½ La Herradura, Santiago de los Caballeros, República Dominicana. ORCID: 0000-0002-0725-9854. Correo-e: ebobadilla@isa.edu.do